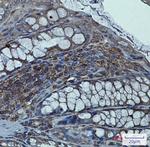
SNTA1 Antibody in Immunohistochemistry (Paraffin) (IHC (P))

Search
Abnova
SNTA1 Recombinant Rabbit Monoclonal Antibody
{{$productOrderCtrl.translations['antibody.pdp.commerceCard.promotion.promotions']}}
{{$productOrderCtrl.translations['antibody.pdp.commerceCard.promotion.viewpromo']}}
{{$productOrderCtrl.translations['antibody.pdp.commerceCard.promotion.promocode']}}: {{promo.promoCode}} {{promo.promoTitle}} {{promo.promoDescription}}. {{$productOrderCtrl.translations['antibody.pdp.commerceCard.promotion.learnmore']}}
产品信息
RAB01879
种属反应
宿主/亚型
Expression System
分类
类型
抗原
偶联物
形式
纯化类型
保存液
内含物
保存条件
运输条件
靶标信息
Syntrophin alpha-1 (Dystrophin, SNTA1) is a large, rod-like cytoskeletal protein found at the inner surface of muscle fibers. Dystrophin is missing in Duchenne Muscular Dystrophy patients and is present in reduced amounts in Becker Muscular Dystrophy patients. The protein encoded by this gene is a peripheral membrane protein found associated with dystrophin and dystrophin-related proteins. This gene is a member of the syntrophin gene family, which contains at least two other structurally-related genes.
仅用于科研。不用于诊断过程。未经明确授权不得转售。
篇参考文献 (0)
生物信息学
蛋白别名: 59 kDa dystrophin-associated protein A1 acidic component 1; acidic alpha 1 syntrophin; Alpha-1-syntrophin; dystrophin-associated protein A1, 59kDa, acidic component; Pro-TGF-alpha cytoplasmic domain-interacting protein 1; RP23-192L3.1; Syntrophin-1; TACIP1; unnamed protein product
基因别名: dJ1187J4.5; LQT12; SNT1; SNTA1; TACIP1
UniProt ID: (Human) Q13424
Entrez Gene ID: (Human) 6640